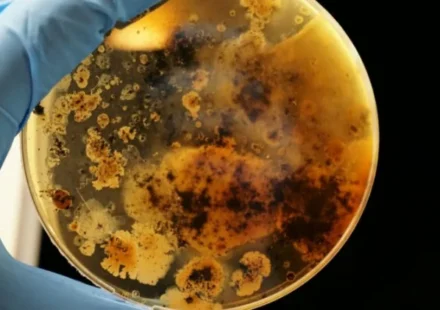

Почему мы изучили всего 1% бактерий на Земле
Остановитесь на минуту и задумайтесь: вокруг нас кипит невидимая жизнь. Бактерии — везде. На коже, в кишечнике, в каждой капле океана и в воздухе, которым мы дышим. Они — и наши невидимые защитники, и причина страшных болезней. Учёные охотятся за ними…
Читать далееРазница между бактериями и вирусами
Какая разница между бактерией и вирусом? Вы можете подумать, что это странный вопрос, поскольку оба являются микроорганизмами, а это означает, что ни один из них не виден невооруженным глазом. И то, и другое может вызвать у нас рвоту, диарею, лихорадку и…
Читать далееНовые антибиотики, которые убивают бактерии совершенно уникальным способом
Исследователи открывают новый тип антибиотиков, которые убивают бактерии, используя уникальный подход. Обычно такие антибиотики, как пенициллин, предотвращают образование бактериальной стенки вокруг их клеток. Новые антибиотики делают наоборот: они…
Читать далееНовая медная поверхность убивает бактерии всего за две минуты
Исследователи разработали новую нанопористую медную поверхность, способную убивать бактерии всего за две минуты. В конечном итоге эта новая структура меди может помочь бороться с растущей угрозой устойчивых к антибиотикам супербактерий. Медь давно…
Читать далееИстория спасения: как случайная плесень изменила мир медицины
У тебя когда-нибудь было сильное воспаление горла? А может, мучила ушная инфекция? Сегодня мы на такие проблемы часто даже внимания не обращаем — выпил таблетку, и порядок. Но ещё каких-то сто лет назад любой порез мог отправить человека в могилу. Что же…
Читать далееОхотятся ли бактерии на других бактерий?
Бактерии могут быть отличными охотниками. Бактерии Bdellovibrio bacteriovorus охотятся на другие бактерии, и как только их бактериальная добыча попадает в их лапы, они начинают ее поедать. Вы наверняка видели сотни видеороликов о том, как хищники…
Читать далееНа Марсе нашли способ вырастить бактерии из местной пыли
Мы привыкли думать о Марсе как о безжизненной пустыне. Холодно, сухо, атмосфера — одно название. Но что, если первые его постоянные жители будут не похожи на нас, а будут микроскопическими? И речь не о гипотетических марсианах, а о земных цианобактериях,…
Читать далееГенетически модифицированные бактерии обыграли ученых в крестики-нолики
html Копировать Скачать Запустить Представьте себе бактерию, которая пытается обыграть вас в крестики-нолики. Звучит как сюжет для научно-фантастического рассказа, не так ли? И тем не менее, ученые умудрились превратить обычную кишечную палочку…
Читать далееНовый многообещающий антибиотик обнаружен в микробиоме кишечника червя
В настоящее время мы остро нуждаемся в новом оружии против инфекционных бактерий, особенно тех, которые относятся к классу, стойкому к смерти, известному как грамотрицательные бактерии. Теперь исследователи из Северо-Восточного университета обнаружили…
Читать далееКак микробы в кишечнике управляют нашим пищеварением
Вы когда-нибудь задумывались, что внутри вас живёт армия численностью 100 триллионов солдат? Звучит как научная фантастика, но это чистая правда. Правда, солдаты эти микроскопические, и они не воюют, а трудятся на благо нашего организма. Например,…
Читать далееУчёные засняли, как бактерии взрывают себя ради спасения колонии
Вы думаете, героизм и самопожертвование — это только про людей и, может быть, про муравьёв? А вот и нет. Оказывается, бактерии тоже способны на коллективный подвиг. Когда на их колонию нападают, некоторые особи сознательно подрывают себя, чтобы спасти…
Читать далееУченые нашли новый метод борьбы с устойчивыми к антибиотикам бактериями
Стресс часто заставляет бактерии образовывать биопленки. Стресс может проявляться в виде физического барьера, ультрафиолета или токсичного вещества, такого как антибиотики. На формирование этих биопленок уходит от нескольких часов до дней, и они могут…
Читать далееПревращаются ли голодные бактерии в каннибалов?
В условиях кризиса у бактерий в рукаве припрятано несколько трюков для выживания. Например, есть бактерии, которые поедают своих сородичей, чтобы выжить в суровых условиях, таких как недостаток питательных веществ. Их каннибализм является настолько…
Читать далееУмный гель из вирусов сам охотится на бактерии и заживает
Представьте себе материал, который буквально кишит вирусами. Звучит как сценарий фильма ужасов? А вот исследователи из Университета Макмастера смотрят на это с большим энтузиазмом. Они создали гель… целиком из вирусов. Но не простых, а тех, для которых…
Читать далее